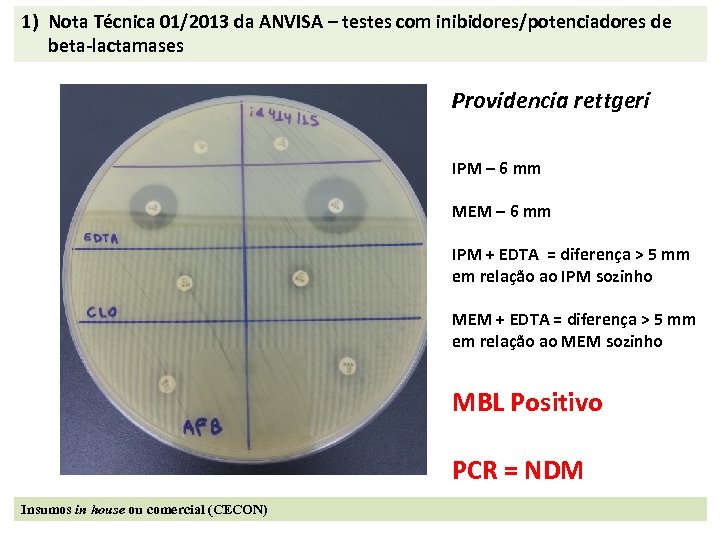
1) Nota Técnica 01/2013 da ANVISA – testes com inibidores/potenciadores de beta-lactamases Providencia rettgeri

0003be84ce172f9a9bbbd6d1e16dc99d.ppt
- Количество слайдов: 24

Técnicas laboratoriais ORIENTAÇÃO PARA A COLETA E PROCESSAMENTO DE CULTURAS DE VIGIL NCIA NOS LABORATÓRIOS DE ORIGEM Elaboração: Cely Silva Mariana Arnoni Doroti de Oliveira Garcia Rosemeire Cobo Zanella

1. SÍTIOS DE COLETA DE CULTURAS DE VIGIL NCIA Micro-organismo Multirresistente MRSA VRE Enterobactérias Resistentes aos Carbapenêmicos Pseudomonas aeruginosa/Acinetobacter spp Resistentes aos Carbapenêmicos Sítio de Coleta 1 Nasal / Nasofaringe Retal Notas: 1. A inclusão de outros sítios de coleta (orofaringe, axilar, inguinal, fezes, lesões, entre outros) aumenta a positividade da pesquisa principalmente nos pacientes em vigência de antibioticoterapia. 2. Por conforto e facilidade pode haver substituição do swab retal pelo perianal. 3. Uma alternativa a ser considerada, frente à recusa da coleta do swab retal, seria a substituição pela coleta de sítio inguinal, com sensibilidade e especificidade inferior - variável para cada espécie.

2. COLETA DE CULTURAS DE VIGIL NCIA 2. 1. Swab Nasal · - Umedecer o swab com salina ou água estéril, ou meio de transporte (Amies, Cary-Blair ou Stuart). · - Inserir o swab na narina anterior e realizar leve rotação. · - Usando o mesmo swab, repetir o procedimento na outra narina. · - Colocar o swab no meio de transporte e identificar com os dados do paciente e sítio de coleta. 2. 2. Swab Retal · - Umedecer o swab com salina, ou água estéril, ou meio de transporte (Amies, Cary-Blair ou Stuart). · - Inserir o swab no reto, cerca de 1 -1, 5 cm e realizar rotação. O material fecal deve ser visível. · - Colocar o swab no meio de transporte e identificar com os dados do paciente e sítio de coleta.

2. 3. Swab Inguinal ou Axilar · Umedecer o swab com salina, ou água estéril, ou meio de transporte (Amies, Cary-Blair ou Stuart). · Rolar ou esfregar gentilmente o swab na região inguinal ou axilar direita, por cerca de 10 segundos. · Usando o mesmo swab, repetir o procedimento do lado esquerdo. . Colocar o swab no meio de transporte e identificar com os dados do paciente e sítio de coleta.

Notas: 1. Se houver indicação da coleta de mais de um sítio, há possibilidade da utilização de um único swab. Neste caso, seguir obrigatoriamente a seguinte ordem de coleta: · Axila direita e esquerda · Região inguinal direita e esquerda · Retal As coletas de narinas devem ser realizadas separadamente, utilizando outro swab. 2. Em pacientes portadores de colostomia, a coleta de swab retal deverá ser substituída por coleta de fezes diretamente da ostomia.

Notas: 3. Avaliar a necessidade de cultura de amostras de urina, secreção traqueal de pacientes em uso de dispositivos invasivos. 4. Na possibilidade da ocorrência de trauma da mucosa coletar fezes. 5. A triagem de Enterobactérias, Acinetobacter baumannii e Pseudomonas aeruginosa resistente aos carbapenêmicos é necessária no manejo de surtos. 6. Para pesquisa direcionada para Acinetobacter spp deve ser incluída a coleta das regiões axiliar e inguinal e na presença de dispositivos invasivos, podem ser incluídas também amostras de urina e vias respiratórias. 7. Os pedidos de exame deverão informar que se trata de cultura de vigilância.

3. TRANSPORTE · As amostras em swab com meio de transporte devem ser encaminhadas ao laboratório de origem o mais rápido possível. · Os swabs podem ser mantidos por até 24 horas em temperatura ambiente ou 48 horas sob-refrigeração (2 -8°C). 4. PROCESSAMENTO 4. 1. SEMEADURA · As amostras de cultura de vigilância de diferentes sítios de um mesmo paciente podem ser processadas separadamente ou em conjunto. · Se o processamento for em conjunto, os swabs devem ser inoculados em meio líquido, tais como, salina estéril, caldo BHI ou caldo TSB e seguir a rotina indicada para cada micro-organismo a ser pesquisado.

4. 2. PROCEDIMENTO, LEITURA E INTERPRETAÇÃO MEIOS DE CULTURA: Podem ser utilizados meios seletivos ou meios cromogênicos com antimicrobianos incorporados à formulação. A utilização de meios cromogênicos aumenta a sensibilidade e especificidade do teste quando comparada aos meios tradicionais adicionados de antimicrobianos, além de reduzir o trabalho e otimizar o tempo de análise.

4. 2. PROCEDIMENTO, LEITURA E INTERPRETAÇÃO SEMEADURA A semeadura pode ser feita por esgotamento ou pela técnica de “spot”, seguida da aplicação de discos de antimicrobianos no início e no final das estrias. A critério, a rotina para a pesquisa de resistência aos carbapenêmicos para enterobactérias pode incluir uma etapa de préenriquecimento da amostra em caldo com 0, 25 mg /m. L de ertapenem + 100 mg /m. L de ampicilina (para minimizar o crescimento de Enterococcus spp) ou, alternativamente, pode ser adicionado um disco de ertapenem (10 mg) a 10 m. L de caldo TSB ou similar, imediatamente antes do uso; após 16 -18 h de incubação a 35 -37 C, realizar sub-cultivo em agar Mac. Conkey por esgotamento, aplicando em seguida discos de ertapenem no início e final das estrias. Vide tabela para outros micro-organismos.

Procedimento, Leitura e Interpretação Agente MR Leitura Agar Mueller Hinton + 4% de Na. Cl + Oxacilina 6µg/m. L 1 Crescimento > 1 colônia após 24 horas de incubação Meios seletivos para Gram positivo + oxacilina 6µg/m. L 2 MRSA Meio Crescimento Meio Cromogênico MRSA Agar BHI + vancomicina 6µg/m. L 1 VRE Crescimento na coloração especificada Crescimento > 1 colônia após 24 horas de incubação Confirmação laboratorial Não Sim 3 Sim 5 Crescimento Sim 5 Meio Cromogênico VRE Crescimento na coloração especificada Crescimento em halo ≤ 27 mm Sim 6 Agar Mac. Conkey + 1 -2 mg/m. L de imipenem Crescimento Sim 6 Meio Cromogênico ESBL + discos de Ertapenem Crescimento na coloração especificada e em halo ≤ 27 mm Sim 6 Meio Cromogênico KPC Agar Mac. Conkey + discos para técnica de disco aproximação Meio Cromogênico ESBL Crescimento na coloração especificada Expansão da zona do halo em direção ao disco de amoxacilina+ clavulanato 8 Crescimento na coloração especificada 8 Acinetobacter baumannii resistentes aos carbapenêmicos _____ resistente aos carbapenêmicos 7 Sim 6 Sim 8 Agar Mac. Conkey + 2 mg/m. L de cefotaxima Pseudomonas aeruginosa resistentes aos carbapenêmicos Pesquisa de Enterococcus spp resistente a vancomicina (VRE): positiva Sim 5 Agar Mac. Conkey + discos de Ertapenem ESBL Pesquisa de Staphylococcus aureus resistente a oxacilina (MRSA): positiva Sim 4 Meios seletivos para Gram positivo + vancomicina 6µg/m. L 2 ECR Interpretação Crescimento Sim 8 Agar Mac. Conkey + discos de Imipenem Crescimento em halo 20 mm Sim 9 Agar Mac. Conkey + 1 -2 mg/m. L de imipenem Crescimento Sim 9 Agar Mac. Conkey + discos de Imipenem Crescimento em halo 23 mm Não 10 Agar Mac. Conkey + 1 -2 mg/m. L de imipenem Crescimento Não 10 _____ produtora de betalactamase de espectro ampliado 7 P. aeruginosa produtora de metalobetalactamase A baumannii resistente aos carbapenêmicos

Notas: 1. Meio de cultura indicado para cepas previamente isoladas e identificadas como S. aureus ou como Enterococcus spp. 2. MRSA: Agar Chapman, Manitol, Azida, etc. VRE: Azida, Agar Bilesculina com vancomicina, entre outros. 3. Confirmar identificação do micro-organismo como Staphylococcus aureus e susceptibilidade a cefoxitina conforme CLSI vigente. 4. Confirmar identificação do micro-organismo como Staphylococcus aureus. 5. Confirmar identificação do micro-organismo e susceptibilidade a vancomicina conforme CLSI vigente. Se possível, identificar a espécie para diferenciar a resistência adquirida da intrínseca (Enterococcus gallinarum e Enterococcus casseliflavus).

Notas: 6. Seguir as recomendações da Nota Técnica Nº 01/2013 – Medidas de prevenção e controle de infecções por enterobactérias multiresistentes da ANVISA. Disponível em: http: //portal. anvisa. gov. br/wps/wcm/connect/a 891 dd 004 fbdebfcb 9 e 0 fd 9 a 71 d cc 661/NOTA+001+013. pdf? OU utilizar outros métodos rápidos para a detecção de carbapenemases, tais como, CARBA-NP, Blue CARBA, Kit Carbapenem. Bac e Carbapenem. Bac Metalo (Probac), Rapidec (Biomerieux) e Kit para detecção de carbapenemases (CECON). 7. Identificação da enterobactéria. Exemplos: Klebsiella pneumoniae, Escherichia coli, Enterobacter spp, entre outras. 8. Identificar o micro-organismo e seguir as orientações do CLSI vigente. 9. Realizar o teste fenotípico com agentes quelantes de íons (EDTA, ácido mercaptopropiônico) para a detecção de metalo-betalactamase. 10. Confirmação de produção de carbapenemases somente por métodos genotípicos.

4. 3. Confirmação da resistência aos carbapenêmicos em enterobactérias: Seguir as orientações da Nota Técnica ANVISA no 01/2013 quanto às medidas de prevenção e controle de infecções por enterobactérias multirresistentes. Disponível em: http: //portal. anvisa. gov. br/wps/wcm/connect/ea 4 d 4 c 004 f 4 ec 3 b 98925 d 9 d 785 749 fbd/Microsoft+Word++NOTA+T%C 3%89 CNICA+ENTEROBACTERIAS+17+04+2013(1). pdf? MOD=AJPE RES Alternativamente, podem ser utilizadas metodologias de detecção rápida de carbapenemases, tais como CARBA-NP, Blue-Carba, Rapidec (Biomerieux), Cabapenem. Bac e Carbapenem. Bac Metalo (Probac) ou Kit para detecção de carbapenemases (Cecon).

Leitura e interpretação dos testes de sensibilidade aos antimicrobianos PARA ENTEROBACTÉRIAS RESISTENTES AOS CARBAPENÊMICOS A identificação de uma enterobactéria resistente aos carbapenêmicos já deve levar a adoção de medidas específicas de acordo com a epidemiologia local. Utilizar os critérios interpretativos para avaliação da sensibilidade de enterobactérias contidos no item C da Nota Técnica no 01/2013 da ANVISA, em sua Tabela 1: http: //portal. anvisa. gov. br/wps/wcm/connect/ea 4 d 4 c 004 f 4 ec 3 b 98925 d 9 d 785749 fbd/Microsoft+ Word++NOTA+T%C 3%89 CNICA+ENTEROBACTERIAS+17+04+2013(1). pdf? MOD=AJPERES Tabela 1 – Critérios interpretativos a serem utilizados em substituição/complementação àqueles definidos nos documentos do CLSI para testes de sensibilidade de enterobactérias CIM Antimicrobiano Disco-Difusão Sensível Intermediári Resistente Potência Sensível Intermediário Resistente (mg/m. L) o (mg/m. L) do disco (mm) (mg) Aztreonam 1 2 -4 8 30 24 21 -23 20 Cefepima 1 2 -4 8 30 24 21 -23 20 19 -21 A 18 A 1 Ertapenem Colistina ou 2 -4 8 10 A 0, 5 Ceftazidima A 22 A 1 2 10 25 22 -24 21 2 _ 4 _ B _ _ _ 1 2 4 15 18 C 15 -17 C 14 C Polimixina B Tigeciclina • A concentração do disco difere daquele usualmente comercializado pela maioria dos fabricantes. • O método de Kirby-Bauer (disco-difusão) não é adequado para a avaliação da susceptibilidade às polimixinas. • Os critérios interpretativos para tigeciclina, quando testada pelo método de Kirby-Bauer, estão disponíveis apenas para E. coli. Para outras espécies bacterianas deve ser determinada a concentração inibitória mínima. A tigeciclina tem atividade reduzida contra enterobactérias dos gêneros Morganella, Providencia e Proteus.


SCREENING INICIAL PARA A DETECÇÃO DE CARBAPENEMASES TESTES FENOTÍPICOS ENTEROBACTÉRIAS PARA A DETECÇÃO DE CARBAPENEMASES EM 1) Nota Técnica 01/2013 da ANVISA – testes com inibidores/potenciadores de beta-lactamases KPC – inibida pelo AFB MBL – inibida pelo EDTA Amp. C – potencializada pela cloxaciclina

Painel para o teste com inibidores de beta-lactamases em enterobactérias (NT Anvisa 01/2013) Legenda: ERT: ertapenem IMI: imipenem MEM: meropenem
1) Nota Técnica 01/2013 da ANVISA – testes com inibidores/potenciadores de beta-lactamases Providencia rettgeri IPM – 6 mm MEM – 6 mm IPM + EDTA = diferença > 5 mm em relação ao IPM sozinho MEM + EDTA = diferença > 5 mm em relação ao MEM sozinho MBL Positivo PCR = NDM Insumos in house ou comercial (CECON)

Confirmação da resistência aos carbapenêmicos em Pseudomonas aeruginosa: A detecção de produção de metalo-beta-lactamases (MBL) pode ser feita por testes com inibidores de MBL, tais como EDTA e ácido mercapto propiônico (MPA), agentes quelantes de íons zinco presentes na estrutura química das MBLs. Utilizar discos de imipenem (IPM) e ceftazidima (CAZ) com a droga sozinha e outros discos de IPM e CAZ adicionados de 5 ml de EDTA 0, 1 M e 3 ml de MPA, semelhante ao esquema proposto no ítem anterior para enterobactérias. Diferença ≥ 5 mm no tamanho do halo de inibição do disco associado ao inibidor em relação ao disco com a droga sozinha significa presença de metalo-beta-lactamase.

Cepas de Staphylococcus aureus resistentes à oxacilina Cepas suspeitas de resistência à oxacilina deverão ser testadas quanto à susceptibilidade a betalactâmicos através da cefoxitina, segundo orientações do CLSI. Performance Standards for Antimicrobial Susceptibility Testing; Twenty-Sixth Informational Supplement. CLSI document M 100 -S 26. Wayne, PA: Clinical and Laboratory Standards Institute, 2016.

4. 4. Envio das cepas para o Laboratório de Referência – Instituto Adolfo Lutz (IAL) Isolados bacterianos resistentes aos carbapenêmicos: Seguir as orientações de envio de isolados bacterianos resistentes aos carbapenêmicos ao Instituto Adolfo Lutz (IAL) de JUNHO de 2016, encontradas na página do CVE VRE: Seguir as orientações de envio de VRE para o IAL (arquivo JUNHO de 2016) que constam na página do CVE.

Envio das cepas para o Laboratório de Referência Instituto Adolfo Lutz (IAL) Cepas de enterobactérias resistentes aos carbapenêmicos Cepas suspeitas de produção de NDM ou que não se encaixam nos perfis KPC, NDM ou Amp. C ou perfis de resistência atípicos Enviar ao IAL após contato prévio com IAL e DIH/CVE Relacionadas a surtos de IRAS Suspeita de KPC Não Endêmico Enviar ao IAL após notificação on line Enviar ao IAL após contato prévio com IAL e DIH/CVE Enviar ao IAL apenas em situações especiais e após contato prévio com IAL e DIH/CVE

Envio das cepas para o Laboratório de Referência Instituto Adolfo Lutz (IAL) Cepas de P. aeruginosa e Acinetobacter resistentes aos carbapenêmicos Relacionadas a surtos de IRAS Enviar ao IAL após notificação on line

Em caso de dúvida entrar em contato com a Divisão de Infecção Hospitalar/CVE ou com o Centro de Bacteriologia/IAL. Divisão de Infecção Hospitalar/CVE Email: dvhosp@saude. sp. gov. br Telefones: 11 – 3066 -8759/3066 -8261 Centro de Bacteriologia/IAL E-mail: bacteriologia@ial. sp. gov. br; Doroti de Oliveira Garcia (resistência aos carbapenêmicos) dogarcia@yahoo. com; dogarcia@ial. sp. gov. br Fone: 11 -3068 -2896 Rosemeire Cobo Zanella (VRE) cobo@ial. sp. gov. br Fone: 11 - 3068 -2894
0003be84ce172f9a9bbbd6d1e16dc99d.ppt